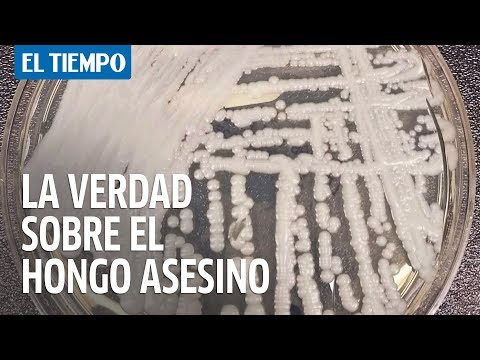

30/11/2014
Tipos de hongos en orina
- Introducción
- Tipos de hongos en orina
-
Preguntas frecuentes
- ¿Es contagiosa una infección fúngica en la orina?
- ¿Qué factores aumentan el riesgo de desarrollar una infección fúngica en la orina?
- ¿Cómo se diagnostica una infección fúngica en la orina?
- ¿Cuál es el tratamiento para una infección fúngica en la orina?
- ¿Se puede prevenir una infección fúngica en la orina?
- Conclusión
Introducción
Los hongos en la orina son un tipo de infección fúngica que puede afectar a cualquier persona, independientemente de su género o edad. Estas infecciones son causadas por la proliferación de ciertos tipos de hongos en el tracto urinario, usualmente como resultado de una mala higiene o de un sistema inmunológico debilitado. En este artículo, exploraremos los diferentes tipos de hongos que pueden encontrarse en la orina y cómo pueden ser tratados.
Es fundamental entender que las infecciones de hongos en la orina son un problema de salud que debe ser tratado adecuadamente para evitar complicaciones adicionales. Siempre es recomendable consultar a un médico para obtener un diagnóstico preciso y un plan de tratamiento adecuado.
A continuación, enumeraremos los tipos más comunes de hongos que pueden encontrarse en la orina y proporcionaremos una breve descripción de cada uno de ellos.
Tipos de hongos en orina
-
Hongo tipo 1
Este tipo de hongo es uno de los más frecuentes en las infecciones urinarias. Se caracteriza por la presencia de síntomas como micción dolorosa, necesidad frecuente de orinar y orina turbia o con un olor fuerte.
-
Hongo tipo 2
Otro tipo común de hongo en la orina. Sus síntomas incluyen dolor en la zona abdominal, fiebre y en algunos casos, sangre en la orina.
-
Hongo tipo 3
Este hongo en particular afecta principalmente a las personas con sistemas inmunológicos debilitados, como aquellas que padecen VIH/SIDA. Sus síntomas pueden incluir dolor al orinar, fiebre alta y debilidad generalizada.
-
Hongo tipo 4
Este tipo de hongo se caracteriza por una multiplicación rápida en el tracto urinario, lo que puede llevar a una infección grave si no se trata adecuadamente. Los síntomas habituales son dolor al orinar, necesidad urgente de orinar y fiebre.
-
Hongo tipo 5
El hongo tipo 5 es conocido por su alta resistencia a los tratamientos antifúngicos convencionales. Es importante tratar esta infección de manera oportuna para evitar complicaciones adicionales.
-
Hongo tipo 6
Este tipo de hongo en la orina suele afectar más a las mujeres que a los hombres y se caracteriza por la presencia de síntomas como picazón intensa, flujo vaginal anormal y ardor al orinar.
-
Hongo tipo 7
El hongo tipo 7 es más común en personas con diabetes, ya que el azúcar en la orina proporciona un medio de cultivo ideal para su crecimiento. Los síntomas incluyen micción frecuente, sed excesiva y cansancio.
-
Hongo tipo 8
Este tipo de hongo en la orina puede causar dolor intenso en el área de la vejiga y requerir un tratamiento prolongado para lograr la curación completa.
-
Hongo tipo 9
El hongo tipo 9 suele ser más frecuente en personas que han recibido recientemente tratamiento con antibióticos de amplio espectro. Los síntomas incluyen micción dolorosa, urgencia y aumento de la frecuencia urinaria.
-
Hongo tipo 10
Este tipo de hongo en la orina es menos común pero puede presentar síntomas graves como fiebre alta, escalofríos y dolor en los riñones.
Preguntas frecuentes
-
¿Es contagiosa una infección fúngica en la orina?
No, las infecciones fúngicas en la orina no suelen transmitirse de persona a persona.
-
¿Qué factores aumentan el riesgo de desarrollar una infección fúngica en la orina?
Algunos factores que pueden aumentar el riesgo incluyen una mala higiene, un sistema inmunológico debilitado, diabetes, obstrucción urinaria y el uso prolongado de antibióticos.
-
¿Cómo se diagnostica una infección fúngica en la orina?
Un médico puede solicitar un análisis de orina para detectar la presencia de hongos y determinar el tipo específico de infección.
-
¿Cuál es el tratamiento para una infección fúngica en la orina?
El tratamiento generalmente involucra el uso de medicamentos antifúngicos, así como medidas para fortalecer el sistema inmunológico y mejorar la higiene personal.
-
¿Se puede prevenir una infección fúngica en la orina?
Sí, algunas medidas de prevención incluyen mantener una buena higiene personal, evitar el uso excesivo de antibióticos y mantener un sistema inmunológico saludable a través de una alimentación balanceada y ejercicio regular.
Conclusión
En conclusión, las infecciones fúngicas en la orina son un problema de salud que puede afectar a cualquier persona. Es importante reconocer los diferentes tipos de hongos que pueden encontrarse en la orina y buscar tratamiento médico adecuado para evitar complicaciones.
Agradecemos a nuestros lectores por su atención y los invitamos a compartir sus experiencias, preguntas y comentarios relacionados con este tema en la sección de comentarios a continuación. Sus opiniones son valiosas para nosotros y para otros lectores que busquen información sobre este tema.
Si quieres conocer otros artículos parecidos a Tipos de hongos en orina puedes visitar la categoría Medicina.

Conoce mas Tipos